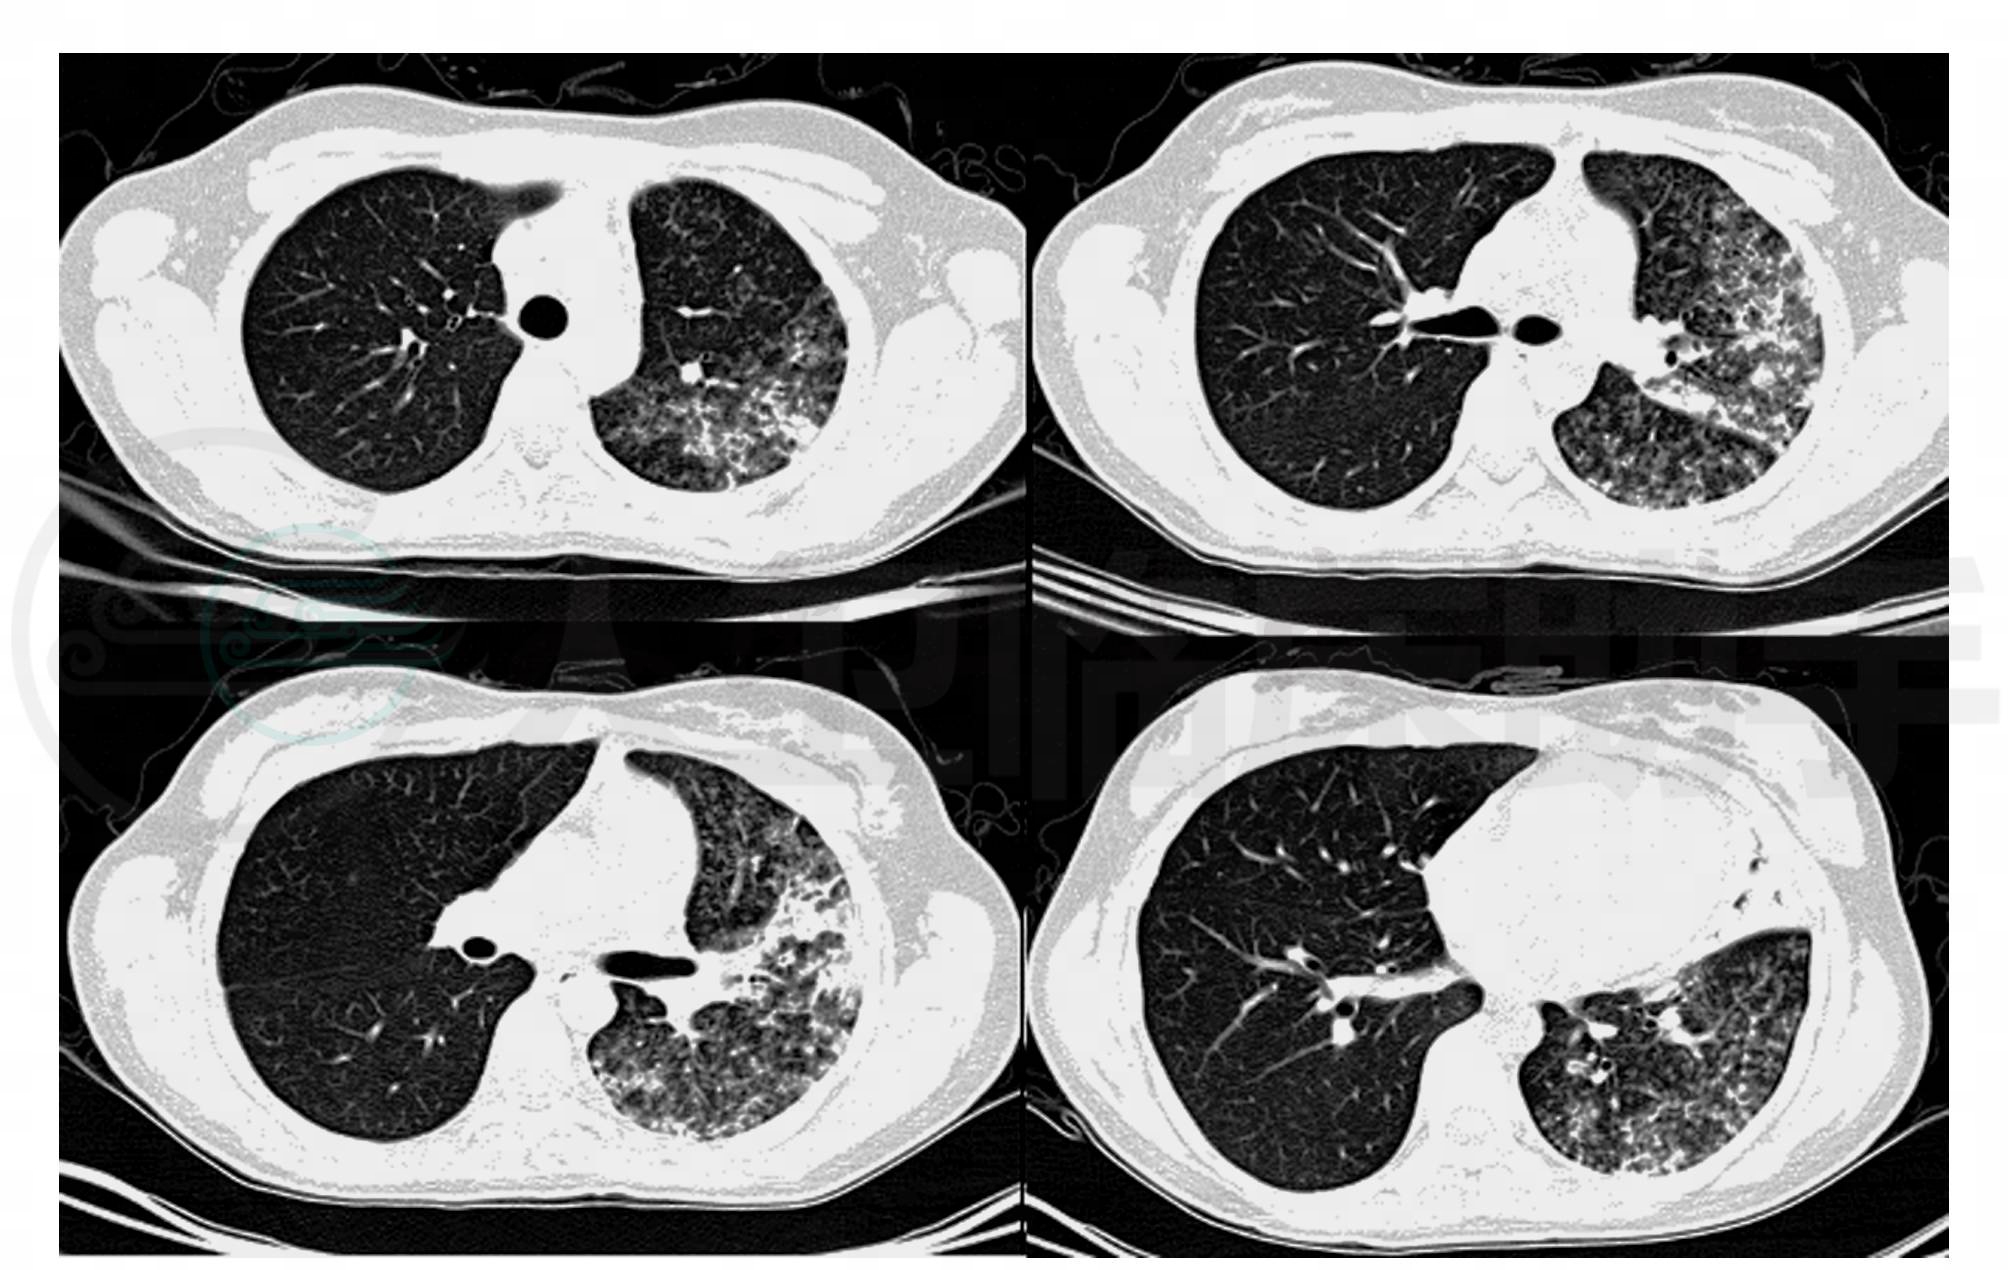

肺结核(pulmonary tuberculosis)在21世纪仍然是严重危害人类健康的主要传染病,是全球关注的公共卫生问题和社会问题,也是我国重点控制的主要疾病之一。在我国结核病呈高感染率,年结核分枝杆菌感染率为0.72%,城市人群高于农村;高患病率,2000年数据显示活动性肺结核患病率367/10万,患病以中青年多见,15~59岁年龄段的涂阳肺结核患者数占61.6%。结核病疫情非常严峻。
女患,15岁,2008年9月18日,以“咽痛、发热9天,咳嗽3天”为主诉入院。9天前受凉后患者出现咽痛,伴发热,体温最高39.5摄氏度,无畏寒寒战,无鼻塞,无咳嗽咳痰,家属予扑热息痛、感冒胶囊治疗,后加用炎琥宁抗病毒治疗4天,症状无改善,并出现咳嗽,无痰,于社区诊所就诊,诊断为“上呼吸道感染”,予头孢类抗生素联合红霉素治疗3天,患者觉咽痛症状有所缓解,但仍有发热,咳嗽无咳痰,为求进一步诊疗来。患者近来饮食睡眠可,二便无异常,体重无变化。
入院查体:T 38.8℃,BP 105/65mmHg,P 120次/分,R 19次/分,口唇无发绀,左肺中上部呼吸音弱,可闻及中小水泡音,心音纯正,律齐,各瓣膜区未闻及病理性杂音。腹平软,无压痛及反跳痛,肝脾肋下未触及,双下肢无水肿。
入院辅助检查:2008年9月18日血常规:WBC5.6×109/L,中性粒64.3%;肺炎支原体抗体1∶160;CRP 66.5ng/L;动脉血气分析:氧分压72.6mmHg;肺CT:左肺炎症(图1);心电图示窦性心动过速。

图1 2008年9月18日
入院诊断:社区获得性肺炎,支原体肺炎可能性大。
治疗经过及疾病变化:2008年9月18日至21日,给予阿奇霉素联合一代头孢菌素,患者仍发热,每日最高体温在39.5摄氏度左右,没有下降趋势。
考虑到肺炎支原体对阿奇霉素耐药率不断增加的情况,及患者未满18岁,不宜使用喹诺酮类抗生素,从9月22日开始换用红霉素联合哌拉西林/他唑巴坦治疗,直到9月28日患者体温仍无下降趋势。期间反复进行血细菌培养3次,阴性结果;复查血常规WBC 10.4×109/L,NE 77.5%;CRP 70.5ng/ L;肺CT;影像改变不明显(图2)。

图2 2008年9月28日
9月29日将抗生素调整为利奈唑胺0.6g,每12小时一次,静点,联合哌拉西林/他唑巴坦,患者在第二天,也就是9月30日,体温即降至正常范围,10 月2日停用哌拉西林/他唑巴坦,单独应用利奈唑胺治疗,患者体温也没有再次升高,咳嗽症状消失。其间复查1次肺CT,炎症渗出影像有所吸收(图3);复查动脉血气分析:氧分压升高至90.3mmHg;血常规:WBC 5.7×109/L,NE 67.3%;CRP 30.1ng/ L。支原体抗体:1∶160。利奈唑胺应用至10月19日,共21天,患者停药出院。
图3 2008年10月18日
患者出院后第4天,也就是10月24日开始再次出现发热,体温最高在38.5℃左右,多在下午时开始发热,于夜晚体温自行下降,并再次出现咳嗽症状,仍无痰。
2008年11月3日,患者再次入院。查体没有明显阳性体征发现。辅助检查:2008年10月29日血常规:WBC:10.2×109/L,NE%:64.10%,RBC:4.25×1012/L,HB:126g/L,PLT:257×109/L;肺CT:左肺感染性病变,较前未见好转,左肺病变合并多发空腔(肺气囊?)或空洞形成(图4)。治疗给予万古霉素,应用3天。患者体温及咳嗽症状没有明显改善。建议患者抗结核治疗,半月后体温正常,规范治疗半年,停药,未再发。

图4 2008年10月29日
确定诊断:肺结核